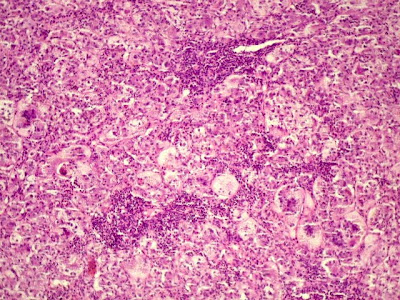

quinta-feira, 27 de agosto de 2009
HEPATITE
Chamamos de hepatite toda inflamação no fígado. Esta inflamação pode ter diversas causas, como veremos a seguir. Com a inflamação, são destruídas células do fígado (hepatócitos e outros), com diversas conseqüências ao organismo. As hepatites podem ter várias causas. As hepatites virais são todas diferentes em sintomas, gravidade e tratamento. Como as mais comuns aqui no Brasil são as causadas por vírus de nomes semelhantes (A, B e C), muitos pensam que são parecidas. Mas isso foi apenas um modo de facilitar o estudo. A hepatite também pode ser causada por infecções generalizadas que acabam por atacar também o fígado, por substâncias tóxicas como o álcool, por erros do nosso próprio sistema imunológico, por mais de um modo diferente e através de outros mecanismos que ainda não conhecemos. Na hepatite aguda, os sintomas podem variar bastante. Dependendo da causa, eles podem não aparecer. Na maioria das vezes, a hepatite aguda surge com um quadro parecido a de uma gripe, com mal estar, fraqueza, febre, dores e náuseas. Quadros mais intensos podem vir com icterícia, que é um amarelamento da pele e dos olhos causado pelo acúmulo de bile no sangue. Além dos sintomas habituais, surgem alterações de comportamento, sonolência e confusão, sinais de que o fígado não está conseguindo eliminar toxinas do organismo (encefalopatia hepática). Na hepatite crônica, ocorre uma destruição lenta das células do fígado, que aos poucos vão se regenerando ou formando cicatrizes. Nessa fase, praticamente não há sintomas. Por esse motivo, muitas pessoas não descobrem a doença até que seja tarde demais. O que acontece é que a destruição das células do fígado pode chegar a um ponto em que a regeneração não é mais possível e o fígado pode não ser mais capaz de funcionar normalmente. Isso, junto com a formação de cicatrizes no fígado, é o que chamamos de cirrose
Icterícia Neonatal

A Icterícia neonatal é uma patologia que ocorre em recém-nascidos em conseqüência do aumento de bilirrubina indireta (hiperbilirrubinemia) na corrente sangüínea, sendo sua manifestação clínica a icterícia, isto é, a pele e as mucosas tornam-se amareladas. Ocorre em cerca de 50% dos recém-nascidos a termo e em 70% do recém-nascido pré-termo (prematuros). Em geral a bilirrubina indireta está firmemente ligada à albumina mas pode separar-se dela e circular livremente no sangue, tornando-se então perigosa, principalmente quando atinge níveis acima de 5 mg%, por ser neurotóxica. A bilirrubina livre difunde-se para o interior das células, intoxicando-as e causando sua morte.
segunda-feira, 24 de agosto de 2009
VITILIGO

O que é?
É uma doença caracterizada pela despigmentação da pele, formando manchas acrômicas de bordas bem delimitadas e crescimento centrífugo. Também é possível que haja despigmentação do cabelo. É freqüente em 1% da população e, em 30% dos casos, há ocorrência familiar. O diagnóstico em doentes com patologias oculares é significantemente maior que na população em geral. Eventualmente, o vitiligo surge após traumas ou queimaduras solares.
Como se adquire?
A causa não está esclarecida, mas há três teorias para explicar a destruição dos melanócitos:
CALCIFICAÇÃO DISTRÓFICA

Como o próprio conceito enfatiza, a calcificação distrófica se relaciona com áreas que sofreram agressões e que apresentam estágios avançados de lesões celulares irreversíveis ou já necrosadas. Nesse último caso, por exemplo, é comum observar calcificações distróficas nas paredes vasculares de indivíduos senis com ateroesclerose, cujo processo se caracteriza por presença de necrose no endotélio vascular devido à deposição de placas de ateroma.
A patogenia da calcificação distrófica ainda não está bem estabelecida; algumas teorias foram criadas em função dos fatores que regulam as calcificações normais, como a teoria dos sabões, aplicável para a ateroesclerose.
sexta-feira, 21 de agosto de 2009
Albinismo


O albinismo é uma condição de natureza genética em que há um defeito na produção pelo organismo de melanina. Este defeito é a causa de uma ausência parcial ou total da pigmentação dos olhos, pele e pêlos do animal afetado. Também aparecem equivalentes do albinismo nos vegetais, em que faltam alguns compostos corantes, como o caroteno. É uma condição hereditária que aparece com a combinação de genes que são recessivos nos pais. O albinismo é uma alteração genética que ocorre nos seres vivos, afetando-lhes a pigmentação. Pode, então, ocorrer, conforme o reino:
• Na Zoologia: Anomalia congênita, caracterizada pela ausência total ou parcial do pigmento da pele, dos pêlos e do olho (a melanina).
• Na Botânica: Anomalia congênita das plantas, consistente na diminuição ou ausência total do caroteno, substância que dá cor à clorofila. O albinismo parcial produz manchas alvas em fundo verde, e corresponde à chamada variegação. Neste caso, o vegetal torna-se ornamental graças à beleza que adquire.
. Os principais tipos de albinismo são os seguintes:
1. Oculocutâneo (completo ou total) - em que todo o corpo é afetado;
2. Ocular - somente os olhos sofrem da despigmentação;
3. Parcial - o organismo produz melanina (ou corantes, se no vegetal) na maior parte do corpo, mas em outras partes isto não ocorre como, por exemplo, nas extremidades superiores.
Papel da melanina - A melanina se distribui por todo o corpo, dando cor e proteção à pele, cabelos e à íris dos olhos. Quando o corpo é incapaz de produzir esta substância, ou de distribuí-la por todo o soma, ocorre a hipopigmentação, conhecida por albinismo.
FAGOCITOSE
A fagocitose é o englobamento e digestão de partículas sólidas e microorganismos por fagócitos ou células amebóides.Na corrente sanguínea ocorre quando o sistema imunológico identifica um corpo estranho que será englobado e digerido pelos leucócitos.Um grande aumento de leucócitos no sangue indica processo infeccioso. Consiste também em processo de alimentação de muitos protozoários unicelulares - onde a partícula englobada pela célula, através da membrana celular, é envolvida num vacúolo digestivo, a partir do qual a matéria digerida passa depois para o citoplasma.A ingestão das partículas de alimento pode ser realizada por pseudópodes, como nos organismos amebóides, ou a própria célula pode ter um citostoma (o mesmo que “boca celular”), como os ciliados, por onde entram as partículas de alimento.
BIOPSIA

A biopsia ou biópsia (do grego bios é vida, e opsis é aparência, visão)é um procedimento cirúrgico no qual se colhe uma amostra de tecidos ou células para posterior estudo em laboratório, tal como a evolução de determinada doença crônica. A biópsia é indicada para: - diagnóstico de doenças que provocam alterações morfológicas(neoplasias, hiperplasia...) - diagnóstico diferencial por exclusão - avaliar a extensão da lesão - estabelecer o grau histológico de malignidade de neoplasia - avaliar o resultado de um tratamento. Como complicações da biópsia podem ocorrer agravamento de lesões neoplásicas malignas devido ao excesso de manipulação, hemorragia, infecção e fistulização.
Tipos de Biopsias:
o Externas: pele e mucosas
o Internas: punção às cegas, punção ecoguiada (órgãos maciços), endoscopias (órgãos ocos)
o Extemporânea (perioperatória)
o Incisional (é retirada apenas uma parte da lesão)
o Excisional: (é retirada a lesão inteira e, em caso de tumores malígnos, retira-se a lesão com uma margem de segurança de, aproximadamente, 2 cm)
o Por aspiração (utilizando-se de seringa, retira-se células de processos tumorais)
NECROSE


Necrose é o estado de morte de um tecido ou parte dele em um organismo vivo. A necrose é sempre um processo patológico e desordenado de morte celular (diferente da apoptose) causado por fatores que levam à lesão celular irreversível e conseqüente morte celular. Alguns exemplos destes fatores são hipóxia/isquemia, agentes químicos tóxicos ou agentes biológicos que causem dano direto ou desencadeiem resposta imunológica danosa, como fungos, bactérias e vírus. A necrose pode ser diferenciada em vários tipos, e cada um está associado a determinado tipo de agente lesivo e determinadas características teciduais após a necrose.
quarta-feira, 19 de agosto de 2009
terça-feira, 18 de agosto de 2009
Apresentação do blog
Mostra quer dizer exposição ou exibição de algo ou parte de algo; e patologia, parte da medicina que estuda as doenças...
Portanto, "Mostra de Patologia" será uma breve exibiçao de assuntos de patologia relacionados aos cuidados de Enfermagem.
As postagens serão feitas pelas acadêmicas de Enfermagem do terceiro período, em 2009.2, da Faculdade Leão Sampaio:
Adriana Kárita
Cícera Cavalcante de Brito
Érica Ferreira Batista
Jósera Macêdo de Morais
Maria Salvina Alencar Costa
Tarcila Helena Gomes Pereira
Portanto, "Mostra de Patologia" será uma breve exibiçao de assuntos de patologia relacionados aos cuidados de Enfermagem.
As postagens serão feitas pelas acadêmicas de Enfermagem do terceiro período, em 2009.2, da Faculdade Leão Sampaio:
Adriana Kárita
Cícera Cavalcante de Brito
Érica Ferreira Batista
Jósera Macêdo de Morais
Maria Salvina Alencar Costa
Tarcila Helena Gomes Pereira
Assinar:
Comentários (Atom)
